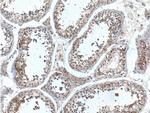
UBXN11 Antibody in Immunohistochemistry (Paraffin) (IHC (P))
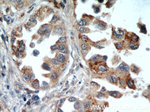
UBXN11 Antibody in Immunohistochemistry (Paraffin) (IHC (P))
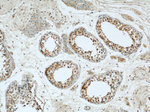
UBXN11 Antibody in Immunohistochemistry (Paraffin) (IHC (P))

Search
Proteintech
UBXN11 Polyclonal Antibody
{{$productOrderCtrl.translations['antibody.pdp.commerceCard.promotion.promotions']}}
{{$productOrderCtrl.translations['antibody.pdp.commerceCard.promotion.viewpromo']}}
{{$productOrderCtrl.translations['antibody.pdp.commerceCard.promotion.promocode']}}: {{promo.promoCode}} {{promo.promoTitle}} {{promo.promoDescription}}. {{$productOrderCtrl.translations['antibody.pdp.commerceCard.promotion.learnmore']}}
产品信息
13109-1-AP
种属反应
宿主/亚型
分类
类型
抗原
偶联物
形式
浓度
规格
纯化类型
保存液
内含物
保存条件
运输条件
产品详细信息
Immunogen sequence: MSSPLASLS KTRKVPLPSE PMNPGRRGIR IYGDEDEVDM LSDGCGSEEK ISVPSCYGGI GAPVSRQVPA SHDSELMAFM TRKLWDLEQQ VKAQTDEILS KDQKIAALED LVQTLRPHPA EATLQRQEEL ETMCVQLQRQ VREMERFLSD YGLQWVGEPM DQEDSESKTV SEHGERDWMT AKKFWKPGDS LAPPEVDFDR LLASLQDLSE LVVEGDTQVT PVPGGARLRT LEPIPLKLYR NGIMMFDGPF QPFYDPSTQR CLRDILDGFF PSELQRLYPN GVPFKVISCS SNHTFGDFEG SGDTQPPQTP PILRGSRCTP WGTPV (1-324 aa encoded by BC038106)
靶标信息
This gene encodes a protein with a divergent C-terminal UBX domain. The homologous protein in the rat interacts with members of the Rnd subfamily of Rho GTPases at the cell periphery through its C-terminal region. It also interacts with several heterotrimeric G proteins through their G-alpha subunits and promotes Rho GTPase activation. It is proposed to serve a bidirectional role in the promotion and inhibition of Rho activity through upstream signaling pathways. The 3' coding sequence of this gene contains a polymoprhic region of 24 nt tandem repeats. Several transcripts containing between 1.5 and five repeat units have been reported. Multiple transcript variants encoding different isoforms have been found for this gene.
仅用于科研。不用于诊断过程。未经明确授权不得转售。
生物信息学
蛋白别名: Colorectal tumor-associated antigen COA-1; colorectal tumor-associated antigen-1; Socius; UBX domain containing 5; UBX domain-containing protein 11; UBX domain-containing protein 5; unnamed protein product
基因别名: 4930506L07Rik; COA-1; D4Bwg1540e; PP2243; SOC; SOCI; UBXD5; UBXN11
UniProt ID: (Human) Q5T124, (Rat) Q8R512, (Mouse) Q9D572
Entrez Gene ID: (Human) 91544, (Rat) 192207, (Mouse) 67586